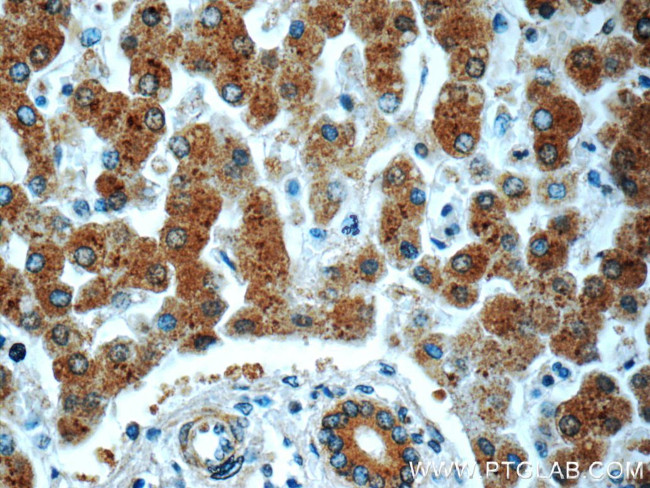
PHKA2 Antibody in Immunohistochemistry (Paraffin) (IHC (P))
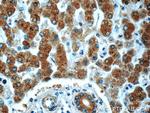
PHKA2 Antibody in Immunohistochemistry (Paraffin) (IHC (P))

Search
Proteintech
PHKA2 Polyclonal Antibody
{{$productOrderCtrl.translations['antibody.pdp.commerceCard.promotion.promotions']}}
{{$productOrderCtrl.translations['antibody.pdp.commerceCard.promotion.viewpromo']}}
{{$productOrderCtrl.translations['antibody.pdp.commerceCard.promotion.promocode']}}: {{promo.promoCode}} {{promo.promoTitle}} {{promo.promoDescription}}. {{$productOrderCtrl.translations['antibody.pdp.commerceCard.promotion.learnmore']}}
产品信息
24658-1-AP
种属反应
宿主/亚型
分类
类型
抗原
偶联物
形式
浓度
规格
纯化类型
保存液
内含物
保存条件
运输条件
产品详细信息
Immunogen sequence: SIAVLTQEI VVYLAMYVRA QPSLFVEMLR LRIGLIIQVM ATELARSLNC SGEEASESLM NLSPFDMKNL LHHILSGKEF GVERSVRPIH SSTSSPTISI HEVGHTGVTK TERSGINRLR SEMKQMTRRF SADEQFFSVG QAASSSAHSS KSARSSTPSS PTGTSSSDSG GHHIGWGERQ GQWLRRRRLD GAINRVPVGF YQRVWKILQK CHGLSIDGYV LPSSTTREMT PHEIKFAVHV ESVLNRVPQP EYRQLLVEAI MVLTLLSDTE MTSIGGIIHV DQIVQMASQL FLQDQVSIGA MDTLEKDQAT GICHFFYDSA PSGAYGTMTY LTRAVASYLQ ELLPNSGCQM Q (886-1235 aa encoded by BC014036)
靶标信息
Phosphorylase b kinase catalyzes the phosphorylation of serine in certain substrates, including troponin I. The alpha chain may bind calmodulin.
仅用于科研。不用于诊断过程。未经明确授权不得转售。
生物信息学
蛋白别名: Phosphorylase b kinase regulatory subunit alpha, liver isoform; phosphorylase kinase; Phosphorylase kinase alpha L subunit; phosphorylase kinase alpha-subunit; RP3-499B10.2; unnamed protein product
基因别名: 6330505C01Rik; D330034O08; GSD9A; PHK; PHKA2; PHKLA; PYK; PYKL; XLG; XLG2
UniProt ID: (Human) P46019, (Mouse) Q8BWJ3
Entrez Gene ID: (Human) 5256, (Mouse) 110094, (Rat) 678739